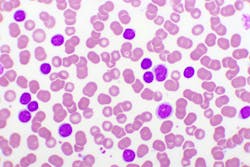
65bd36ec84d21c001e36082e Dreamstime Xxl 161457366 65bd36ec84d21c001e36082e Dreamstime Xxl 161457366

The importance of prognostic testing for patients with chronic lymphocytic leukemia
There are many misconceptions associated with leukemia; while people generally understand that it is a cancer of the blood, most remain unaware of exactly how the disease works. Some believe it is a condition that only affects children (as it is the most common childhood cancer), though two-thirds of all leukemia patients nationwide are over 65 years old.
But leukemia can affect anyone, and the disease is further categorized by providers based on which type of white blood cell is involved (lymphocytes or myeloid cells) and how fast or slow the disease is developing (acutely or chronic).1 As the most common type of leukemia in adults, chronic lymphocytic leukemia (CLL) begins with the development of abnormal lymphocytes in the bone marrow.2,3
About CLL and its diagnosis
The median age at diagnosis is 72. As disease incidence increases with age, incidence is substantially higher in people older than 80. Only about 10% of CLL cases are in people younger than 55.4
Because the leukemic cells multiply slowly at first, most people are asymptomatic for a few years. However, the cells eventually spread to other parts of the body, including potentially the lymph nodes, liver, and spleen. Still, the course of disease for CLL is variable and can be either indolent, with slow progression that may not require treatment, or very aggressive.
How prognostic testing helps CLL patients
Given the complex pathophysiology of this disease, prognostic testing is essential to CLL management. Unlike predictive biomarker testing, which looks at the effectiveness of a patient’s treatment relative to their disease progression, a prognostic biomarker informs about a likely cancer outcome (like disease recurrence or progression) independent of treatment received.5
While most patients may not require therapy in the early stage of the disease, in some patients, CLL can be aggressive. Within a year, tumor mass for this population may increase significantly, imposing serious health problems. It is difficult to determine based on clinical presentation which patient will progress faster than the others. Therefore, there is a need to use accurate prognostic indicators to predict the clinical course of this disease.
Recent advances in CLL therapy and biology have made it possible to develop new tests, and a combination of these tests can be particularly helpful in determining the treatment path for CLL patients. The prognosis for patients with CLL depends on many factors, including prognostic markers, several of which are used to predict survival and guide treatment. Some of these prognostic markers include immunoglobulin heavy-chain variable gene segment mutation status, cell surface markers and chromosomal aberrations.6 Because most cases of CLL are “incurable,” a provider’s main treatment goals are often to prolong survival and maintain or improve quality of life for the patient.4
Testing for prognostic markers of CLL
The wide variation in CLL outcomes makes clinical management of the condition difficult.2 Because clinical management is dependent on the presenting features and disease course, using molecular and immunophenotypic markers to help identify those patients with a higher risk for aggressive disease can help physicians select the optimal treatment and surveillance program at the time of the patient’s initial diagnosis.3
Testing for multiple biomarkers, in this case, is important as many instances of high-risk CLL have abnormal results for several prognostic markers. Few cases, however, demonstrate the presence of all the unfavorable markers. Furthermore, multiple large studies have shown that, although some unfavorable markers are closely correlated to each other, most still have independent prognostic power in multivariate models.2 Therefore, consideration of favorable and unfavorable markers and their relative prognostic power provides the most complete picture of a patient’s risk for aggressive disease.
In a comprehensive CLL Prognostic Panel,7 a patient-specific interpretation that considers the relative prognostic power of the markers detected is provided, so that the test may be used for determining disease prognosis and risk stratification. It includes chromosome analysis, a 6-marker FISH panel, IgVH gene mutation analysis, ZAP-70, CD38, and serum ß2-microglobulin, and generates a patient-specific overall risk categorization based on all the test results.
When combined with routine laboratory studies as well as advanced testing, such as cytogenetics like karyotyping, flow cytometry, mutation analysis, and immunophenotyping, these tests can provide important insights towards both the diagnosis of CLL and the management and follow-up of patients with this disease.
Staying abreast of test results related to CLL is vital, as there are unfavorable complications associated with the disease which, left untreated, can cause other cancers, infections, or immune system dysfunction.2 Diagnosing, staging, and treating the condition properly is vital to a patient’s survival and quality of life, which is why appropriate, accurate, and comprehensive test results are essential for clinicians to obtain.
Conclusion: CLL prognostics are a vital piece of the treatment puzzle
The clinical staging systems for chronic lymphocytic leukemia were developed 40 years ago and remain the backbone of prognostication in clinical practice and trials. As the decision for treatment initiation is supported by these staging systems, providing greater insight through the development of new techniques like next-generation sequencing has been invaluable in helping patients struggling with this disease.8
These innovations have also led to the identification of a variety of novel prognostic markers, which provide complementary information to the classical staging systems. As one example, cytogenetic and molecular genetic investigations of CLL cells have introduced more precise prognostic factors predicting time to treatment and overall survival.8
A significant percentage of CLL patients have an unsatisfactory response to treatment.9 Improving laboratory techniques and remaining abreast of new innovations can help the emergence of new tailored and targeted therapies. Research will continue to involve old and new prognostic markers, to lend new insights into the mechanisms that contribute to the pathogenesis of CLL and to explore therapeutic agents that increase survival expectancy of patients with aggressive disease.
The clinical value of prognostic biomarkers is undisputed for a variety of cancers, though it remains especially true for CLL. With such a complicated disease affecting so many – particularly older patients – predicting outcomes to better understand what course of treatment to take is critical.
The science around cancer continues to evolve, and clinicians have been doing their best to stay on top of these ever-changing developments. Working together, we can ensure patients receive the best care possible, hopefully bettering outcomes from this potentially deadly disease.
References
1. What are the types of leukemia? Memorial Sloan Kettering Cancer Center. Accessed January 29, 2024. https://www.mskcc.org/cancer-care/types/leukemias/types.
2. About chronic lymphocytic leukemia. American Cancer Society. Revised January 12, 2021. Accessed July 18, 2022. https://www.cancer.org/content/dam/CRC/PDF/Public/8679.00.pdf.
3. Chronic Lymphocytic leukemia treatment (PDQ®). National Cancer Institute. Published January 26, 2024. Accessed January 29, 2024. https://www.cancer.gov/types/leukemia/hp/cll-treatment-pdq.
4. Eichhorst B, Robak T, Montserrat E, et al. Chronic lymphocytic leukaemia: ESMO Clinical Practice Guidelines for diagnosis, treatment and follow-up. Ann Oncol. 2021;32(1):23-33. doi:10.1016/j.annonc.2020.09.019.
5. Ballman KV. Biomarker: Predictive or prognostic? J Clin Oncol. 2015;33(33):3968-3971. doi:10.1200/jco.2015.63.3651.
6. National Comprehensive Cancer Network. NCCN Clinical Practice Guidelines in Oncology (NCCN Guidelines®). Chronic lymphocytic leukemia/small lymphocytic lymphoma. Version 3.2022. Published June 3, 2022. Accessed January 29, 2024. https://www.nccn.org/.
7. Quest Diagnostics: Test Directory. Questdiagnostics.com. Accessed January 29, 2024. https://testdirectory.questdiagnostics.com/test/test-detail/17239/chronic-lymphocytic-leukemia-cll-prognostic-panel-comprehensive?q=Chronic%20Lymphocytic%20Leukemia%20(CLL)%20Prognostic%20Panel,%20Comprehensive&cc=MASTER.
8. Eichhorst B, Hallek M. Prognostication of chronic lymphocytic leukemia in the era of new agents. Hematology Am Soc Hematol Educ Program. 2016;2;2016(1):149-155. doi:10.1182/asheducation-2016.1.149.
9. Ivanescu AM, Oprea M, Momanu R, Coles E, Colita A, Lupu AR. Prognosis Factors in Chronic Lymphocytic Leukemia. J Med Life. 2012;5(Spec Issue):48-53.
About the Author

Mark Kruzel, MD, MBA
serves as Medical Director of Oncology for Quest Diagnostics. Dr. Kruzel’s role bridges the gap from assay development to clinical utility, and he works to provide guidance on the appropriate utilization of testing. Dr. Kruzel has extensive research and industry experience ranging from managing an FDA trial site to commercializing a pharmaceutical compound for a start-up company. He has published numerous peer-reviewed journal articles as well as presented abstracts at both local and national conferences. Through his role at Quest, Dr. Kruzel has developed key opinion leader strategies, which help Quest advance the field of precision medicine.